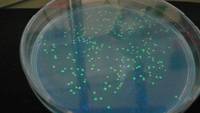

Links zur CTA-Ausbildung
CTA-Album
Bilder aus der CTA-Ausbildung an der ARS von 1989 bis heute...[mehr]
CTA auf Exkursion bei biovis' diagnostics in Limburg
biovis' diagnostics MVZ hat am ICE-Bahnhof in Limburg ein neues Betriebsgebäude errichtet und die angehenden CTA zusammen mit ihrer Lehrerin Sina Bodenheimer zur Besichtigung eingeladen.
Als großer Arbeitgeber in der Region beschäftigt biovis schon seit Jahren mehrere CTA-Absolventen der Adolf-Reichwein-Schule Limburg und informierte die Besucher über die vielfältigen Einsatzmöglichkeiten in der Analytik humanmedizinischer Proben.
Zum Artikel....[ hier klicken]
hier klicken]
Absolvent Dominik Stettler besucht unsere CTA und berichtet von seinem Berufsleben (Juli 2023)
Bericht des Besuches  hier downloaden
hier downloaden
Text und Bild Eva Molsberger, Juli 2023
Erfahrungsberichte von CTA-Absolventen
Erfahrungsberichte CTA-Absolventen ... [![]() mehr]
mehr]
CTA-Nachrichten
Labortechnische Grundoperationen der CT11 im neuen Labor C014

Wie viel % Alkohol enthält Rotwein? Wie hoch ist die Härte des Trinkwassers der Wohngemeinde?
Diese Aufgabenstellungen werden im Rahmen des Lernfeldes "Labortechnische Grundoperationen" in der CT11 bei Herrn Will bearbeitet.
Anhand der entsprechenden amtlichen Verfahren und DIN-Methoden bestimmen die Schüler den Ethanolgehalt von Rotwein und die Wasserhärte ihrer Wohngemeinde und können so die gestellten Fragen eindeutig beantworten.
Die Bestimmung der Volumenkonzentration Ethanol im Wein erfolgt nach Destillation und Dichtebestimmung anhand der amtlichen Alkoholtabellen. Calcium und Magnesium werden komplexometrisch nach den Deutschen Einheitsverfahren titriert.
Diese Beispiele zeigen die praxisnahe Ausbildung der chemisch-technischen Assistenten an der Adolf-Reichwein-Schule bereits im ersten Ausbildungsjahr. Die angehenden CTA werden so früh wie möglich auf Ihren Einsatz in Industrie und Forschung vorbereitet und zu selbstständigem Arbeiten angeleitet.
Zu den Bildern ....[hier klicken]
Text und Bilder: Wolfgang Will, 15.06.2015
Keimzahlbestimmung in Lahnwasser im Februar 2015

Im mikrobiologischen Praktikum bei Herrn Will untersuchen die angehenden chemisch-technischen Assistenten einmal im Jahr die Keimbelastung der Lahn in Limburg. Alle benötigten Nährmedien stellen die CTA selbst her.
Das Lahnwasser wird mit dem Spatelplatten- und dem Gussplattenverfahren parallel untersucht. Die koloniebildenden Einheiten (KBE) - die gleichzusetzen mit den lebensfähigen Bakterien sind - werden per Hand ausgezählt und die KBE-Konzentration mit einem im EDV-Unterricht erarbeiteten Excel-Arbeitsblatt nach ISO 8199 berechnet und auf zwei signifikante Stellen gerundet.
In einem Kolloquium präsentieren und erläutern die CTA Herrn Will ihre Untersuchungsergebnisse. Am 5. Februar 2015 lag die duchschnittliche KBE-Zahl bei ca. 6000 pro Milliliter Lahnwasser. Daraus lässt sich für die Lahn die Gewässergüteklasse II ableiten. Das bedeutet, dass die Lahn bei Limburg mäßig verunreinigt mit noch guter Sauerstoffversorgung und großer Artenvielfalt ist.
Zu den Bildern ....[![]() hier klicken]
hier klicken]
Text: Wolfgang Will, 16.02.2015
Bilder: Wolfgang Will, Marcus Meyer, Christian Klein, 16.02.2015
CT12 im neuen Labor C0-14 bei Herrn Will im Dezember 2014
Nach über 6 Jahren Umbauzeit konnten die chemisch-technischen Assistenten im August 2013 endich in die neuen Labore im Untergeschoss einziehen.
Im Verlauf des Schuljahres 2013-2014 wurde dann der restliche Teil des Chemietraktes der CTA zur offenen Seite des Durchbruches hin fertiggestellt.
Neben drei neuen professionell eingerichteten Laboren zur Wiesbadener Straße hin verfügen wir dort über einen großzügigen Übungsraum, ein Vorbereitungslabor und ein Labor für Gentechnik.
Die Bilder sind im physikalisch-chemischen Praktikum bei Herrn Will im Dezember 2014 entstanden. Alle großen Analysengeräte laufen parallel. Trotzdem haben die Schüler ausreichend Platz. Das Arbeiten und Unterrichten macht jetzt wesentlich mehr Spaß als in den alten Räumen.
Zu den Bildern....[hier klicken]
Text und Bilder: Wolfgang Will, Dezember 2014

Evaluation der CTA-Ausbildung an der Adolf-Reichwein-Schule 2014
Evaluation der CTA-Ausbildung an der ARS durch die Abschlussklasse 2014 (KL Herr Will).. [![]() hier klicken]
hier klicken]

Evaluation der CTA-Ausbildung 2013
Ergebnisse der Evaluation der Ausbildung zum chemisch-technischen Assistenten an der Adolf-Reichwein-Schule durch die Schüler der Abschlussklasse 2013 (KL Frau Dr. Schöpplein) ... [![]() hier klicken]
hier klicken]
Girls-Day bei den CTA 2012 ...[![]() mehr]
mehr]
CT11 auf Gentechnik-Exkursion im X-Lab in Göttingen ...[![]() mehr]
mehr]
CT12 gewinnt Sonderpreis bei "Frieden beginnt im Klassenzimmer"
Die CT12 hat im Rahmen des Deutschunterrichtes bei Frau Meisterburg am Wettbewerb "Frieden beginnt im Klassenzimmer" teilgenommen und am 25.01.2012 den Sonderpreis gewonnen.
Zu den Bildern der Preisverleihung....[![]() hier klicken]
hier klicken]
Ionenchromatograph Metrohm IC 792 für die CTA-Ausbildung
Trinkwasser muss regelmäßig auf den Gehalt verschiedener Anionen, wie z. B. Nitrat und Sulfat, untersucht werden. Eine gängige Analysenmethode für diese Inhaltsstoffe ist die Ionenchromatographie. ...[mehr]
Voltammetrie-Prozessor für die CTA-Ausbildung
In vielen Wohnhäusern liegen zur Trinkwasserversorgung noch alte Bleirohre. Wird eventuell so viel Blei aus den Rohren gelöst, dass der Grenzwert von 4 µg/L überschritten ist?
Diese Frage können die Auszubildenden zum chemisch-technischen Assistenten seit Kurzem beantworten. Aus Sondermitteln des Landes Hessen wurde ein Voltammetrie-Prozessor (VA-Prozessor) der Firma Metrohm für die analytische Ausbildung der CTA angeschafft. ...[![]() mehr]
mehr]
Leica-Mikroskope für die CTA-Ausbildung
Mit Sondermitteln des Landes Hessen konnten im vergangenen Schuljahr neue Mikroskope für die Ausbildung der chemisch-technischen Assistenten (CTA) und der medizinischen Fachangestellten angeschafft werden. Frau Patzak und Herr Will haben das Ausschreibungsverfahren zusammen mit Schulleiter Herr Abel durchgeführt und sich für das Leica Mikroskop DM500 entschieden. Das dies eine gute Wahl war, bestätigt die Auszeichnung des Leica DM500 mit dem Preis „Worlddidact Award 2010“ durch den internationalen Ausbildungsfachverband Worlddidact ... [![]() mehr]
mehr]
Girls-Day bei den CTA 2011 ...[![]() mehr]
mehr]
Madeleine Barta überreicht Spektralphotometer
CTA-Absolventin Madeleine Barta (Abschluss 2004) arbeitet seit über zwei Jahren bei der Firma Gaba International (www.gaba.com) in Therwil/Basel (Schweiz) und überreichte der CTA-Abteilung am 18. Juni 2007 ein hochwertiges Spektralphotmeter (Perkin Elmer), das in ihrer Firma keinen Einsatz mehr findet.
Madeleine macht die Arbeit bei Gaba International großen Spaß. Sie ist dort in der Forschung- und Entwickllung sowie der Qualitätskontrolle eingesetzt. Gaba stellt z. B. die Zahnpasten Elmex und Aronal und die Mundspüllösung Meridol her.
Das Spektralphotometer wird ab dem kommenden Schuljahr im instrumentell-analytischen Praktikum der chemisch-technischen Assistenten an der ARS eingesetzt und stellt eine wertvolle Bereicherung unserer analytischen Großgeräte dar, da die Schülerzahlen in diesem Ausbildungsbereich seit Jahren stark ansteigen.
Die CTA-Abteilung bedankt sich herzlich bei Gaba International und Madeleine Barta für die großzügige Gerätespende!
(ww 18.06.2007)
CTA-Absolventen Ingo Stenzel und Sarah Hölzenbein überreichen uns ein FT-IR-Spektrometer der Firma Abbott (26. Juni 2006)...[mehr]
Informationen zur CTA-Ausbildung an der ARS Limburg
Hier finden Sie vielfältige Informationen rund um die Ausbildung zum chemisch-technischen Assistenten an der Adolf-Reichwein-Schule...[mehr]
Materialien rund um die CTA-Ausbildung
CTA-Stellenangebote, Freeware zu Chemie und Naturwissenschaften, IR-Spektroskopie, Chemie und Analytik, Mikrobiologie, Hygiene und Medizin, Umweltdaten...[mehr]
Messergebnisse aus den CTA-Praktika
Wasserhärte verschiedener Gemeinden, Verkehrslärmmessung, Untersuchung der Lahn, Untersuchung des Wiesensees ...[mehr]
Projekte aus dem Unterricht
Verkehrslärmmessung, Polymerase-Kettenreaktion, Antibiogramme...[mehr]
Naturwissenschaftliche Nachrichten
Aktuelle Zeitungsberichte aus Mikrobiologie, Hygiene, Medizin und verwandten Gebieten ...[mehr]
[weiter]